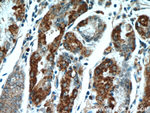
DNAJC10 Antibody in Immunohistochemistry (Paraffin) (IHC (P))
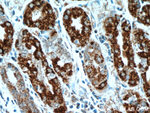
DNAJC10 Antibody in Immunohistochemistry (Paraffin) (IHC (P))
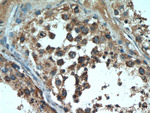
DNAJC10 Antibody in Immunohistochemistry (Paraffin) (IHC (P))
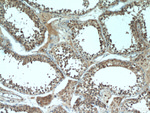
DNAJC10 Antibody in Immunohistochemistry (Paraffin) (IHC (P))

Search
Proteintech
DNAJC10 Polyclonal Antibody
{{$productOrderCtrl.translations['antibody.pdp.commerceCard.promotion.promotions']}}
{{$productOrderCtrl.translations['antibody.pdp.commerceCard.promotion.viewpromo']}}
{{$productOrderCtrl.translations['antibody.pdp.commerceCard.promotion.promocode']}}: {{promo.promoCode}} {{promo.promoTitle}} {{promo.promoDescription}}. {{$productOrderCtrl.translations['antibody.pdp.commerceCard.promotion.learnmore']}}
产品信息
13101-1-AP
种属反应
已发表种属
宿主/亚型
分类
类型
抗原
偶联物
形式
浓度
规格
纯化类型
保存液
内含物
保存条件
运输条件
产品详细信息
The ERdj5 antibody displays a higher affinity for endogenous ERdj5u.
Immunogen sequence: HWVIDFYAP WCGPCQNFAP EFELLARMIK GKVKAGKVDC QAYAQTCQKA GIRAYPTVKF YFYERAKRNF QEEQINTRDA KAIAALISEK LETLRNQGKR NKDEL (690-793 aa encoded by BC034713)
靶标信息
This endoplasmic reticulum co-chaperone may play a role in protein folding and translocation across the endoplasmic reticulum membrane. DNAJC10 may act as a co-chaperone for HSPA5.
仅用于科研。不用于诊断过程。未经明确授权不得转售。
生物信息学
蛋白别名: DnaJ (Hsp40) homolog, subfamily C, member 10; DnaJ homolog subfamily C member 10; Endoplasmic reticulum disulfide reductase DNAJC10; Endoplasmic reticulum DNA J domain-containing protein 5; Endoplasmic reticulum DnaJ-PDI fusion protein 1; ER-resident protein ERdj5; ERDJP-2; J domain-containing PDI-like protein; J domain-containing protein disulfide isomerase-like protein; J-domain-containing protein disulfide isomerase-like protein; Macrothioredoxin; molecular chaperone; MTHr; protein disulfide isomerase family A, member 19; unnamed protein product
基因别名: 1200006L06Rik; D2Ertd706e; DNAJC10; ERDJ5; JPDI; MTHr; PDIA19; UNQ495/PRO1012
UniProt ID: (Human) Q8IXB1, (Rat) Q498R3, (Mouse) Q9DC23
Entrez Gene ID: (Human) 54431, (Rat) 295690, (Mouse) 66861